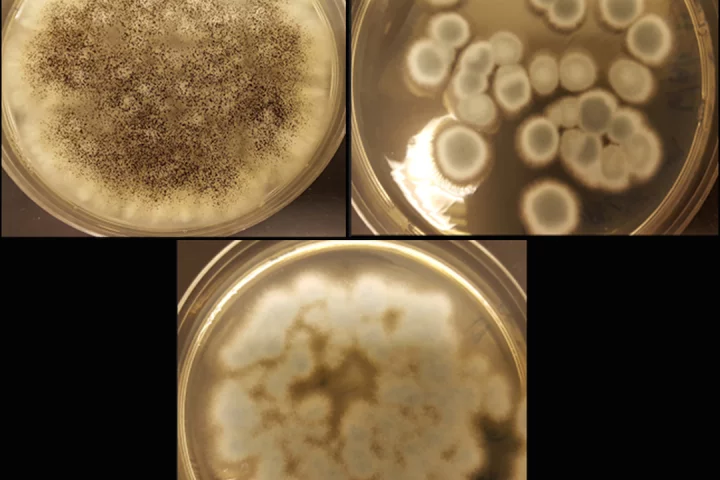
Researchers have used three strains of fungi to extract valuable metals from discarded batteries

Rechargeable Batteries
-
Sodium-ion batteries offer multiple advantages over their lithium-ion cousins. Energy storage, however, isn't one of them. That might be set to change thanks to a new method of creating the batteries involving water-rich cathodes.
-
While lithium extraction technologies generally focus on ways to get the essential metal out of the ground, there's another source to mine: existing batteries that no longer work. A new technique could now make that process economically viable.
-
That plate of smashed crab legs about to be cleared from the dining table and tossed in the trash might actually be the future of rechargeable batteries. A new discovery for its use in sodium-ion technology has researchers certainly believing so.
-
A new battery from MIT uses common materials – aluminum, sulfur and salt. Not only is the battery low-cost, but it’s resistant to fire and failures, and can be charged very fast, making it useful for powering a home or charging electric vehicles.
-
Zinc-air batteries are great little energy storage devices, but they’re not usually rechargeable. Now a team led by the University of Münster has developed a new zinc-air chemistry that makes this type of battery more efficient and rechargeable.
-
Despite advances in new battery designs, good old lithium-ion batteries are still the frontrunner. There’s plenty of room for improvement though, and now researchers have identified a new cathode coating that could make them safer and longer lasting.
-
California's Enevate says it's managed not only to achieve an incredibly fast-charging solution for lithium-ion EV batteries, but one that handily boosts energy density as well. Using silicon anodes, it could give you 250 miles of range in 5 minutes.
-
At 50 percent smaller by volume than a typical lithium-ion battery, Samsung's prototype solid-state pouch cells could enable 500-mile electric car ranges and cycle lives over 1,000 charges in a much safer package.
-
A new study shows how fluoride might be put to work in better batteries. Researchers at Caltech, JPL, Lawrence Berkeley National Lab and the Honda Research Institute have developed fluoride-based batteries that could potentially last much longer than existing lithium-ion-based devices.
-
After a few weeks with the SwitchCharge, a beefy battery pack for the Nintendo Switch, we’re happy to report that it actively solves some of Nintendo’s niggles, earning its place in our bag basically every time we leave the house with the Switch.
-
Researchers are exploring the difficult task of reclaiming lithium from old discarded batteries. A new study has put three strains of fungi to work to extract these valuable materials from electronic waste, which could lead to a safer and greener battery recycling system.
-
By eliminating the need for traditional separator membranes, researchers have created printable solid-state batteries that can be printed in any conceivable shape and can be seamlessly embedded into a variety of surfaces.
Load More